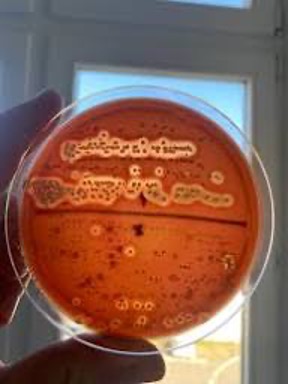

Використання цифрових технологій на уроках біології та основ здоров’я
20.02.2025
Протокол №1, 2025 рік
У межах діяльності студентського наукового гуртка «Сучасні технології навчання біології» було ґрунтовно розглянуто питання впровадження цифрових технологій у процес навчання біології та основ здоров’я як одного з провідних напрямів модернізації сучасної шкільної освіти. Цифровізація освітнього середовища розглядається як умова формування ключових і предметних компетентностей здобувачів освіти відповідно до вимог Нової української школи.
Доповідачка — Софія ВАНЬ, магістр спеціальності «Середня освіта (Біологія та здоров’я людини)», представила результати науково-методичного дослідження щодо формування цифрового методичного комплексу з біології. Особливу увагу було приділено використанню технології BYOD, інтерактивних освітніх платформ, онлайн-тестування, цифрових візуалізацій та мобільних застосунків. Доведено, що системне використання цифрових ресурсів сприяє індивідуалізації навчання, розвитку пізнавальної активності учнів та підвищенню мотивації до вивчення біології.
Науковий керівник гуртка Сергій СКРИПНИК, доцент кафедри екології та біологічної освіти, кандидат педагогічних наук, наголосив, що цифрові технології є ефективним інструментом реалізації компетентнісного та діяльнісного підходів у шкільному курсі біології.
Результати роботи гуртка опубліковано у фахових виданнях та поширено в соціальних мережах.

Використання віртуальних лабораторій при вивченні біології (продовження)
20.03. 2025.
Протокол №2
Важливим напрямом роботи студентського наукового гуртка «Сучасні технології навчання біології» стало дослідження можливостей використання віртуальних лабораторій у процесі вивчення біології. Цифрові лабораторні середовища розглядаються як ефективний інструмент поєднання теоретичних знань із практичною діяльністю здобувачів освіти.
Запрошена гостя — Олександра УКРАЇНЕЦЬ, керівник фірми Sanimed-m у місті Хмельницькому, представила практичний досвід використання віртуальних лабораторій під час проходження пропедевтичної, педагогічної та переддипломної практик студентів. Було продемонстровано можливості цифрового моделювання біологічних експериментів, зокрема з клітинної біології, мікробіології, фізіології та генетики.
Під керівництвом Сергія СКРИПНИКА учасники гуртка дійшли висновку, що віртуальні лабораторії забезпечують безпечність освітнього процесу, знижують матеріальні витрати та сприяють формуванню практичних навичок дослідницької діяльності.

«Життя під мікроскопом»: дослідницька діяльність на уроках біології
Протокол №3
24.04.2025.
У межах діяльності гуртка «Сучасні технології навчання біології» значну увагу приділено розвитку дослідницької діяльності учнів як складової компетентнісного навчання біології. Дослідницький підхід сприяє формуванню наукового світогляду, критичного мислення та практичних умінь.
Керівник гуртка Сергій СКРИПНИК представив методичні підходи до організації лабораторних робіт, зокрема дослідження пігментів рослин, витяжки хлорофілів, вивчення властивостей крохмалю та мікроскопічної будови клітин. Акцентовано увагу на формуванні в учнів умінь планувати експеримент, висувати гіпотези, аналізувати результати та формулювати висновки.
Учасники засідання відзначили, що залучення учнів до експериментальної діяльності підвищує інтерес до вивчення біології та сприяє усвідомленому засвоєнню навчального матеріалу.


«Пізнаємо природу» для 5 класу: міждисциплінарний підхід
Протокол №4
Під час засідання гуртка «Сучасні технології навчання біології» було детально проаналізовано особливості впровадження інтегрованого курсу «Пізнаємо природу» для учнів 5 класу. Курс розглядається як ефективний засіб формування цілісної природничо-наукової картини світу.
Сергій СКРИПНИК наголосив на доцільності використання трансдисциплінарного підходу, який поєднує знання з біології, екології, географії, фізики та основ здоров’я. Такий підхід сприяє розвитку системного мислення, дослідницьких умінь і пізнавальної самостійності учнів.
Інтегрований характер курсу дозволяє реалізувати міжпредметні зв’язки, підвищити практичну спрямованість навчання та сформувати ключові компетентності відповідно до концепції Нової української школи.

Планування та організація діяльності студентського наукового гуртка
Протокол №5
25.09.2025. Засідання гуртка «Сучасні технології навчання біології» було присвячене стратегічному плануванню діяльності студентського наукового гуртка та визначенню пріоритетних напрямів науково-дослідної роботи.
Під керівництвом Сергія СКРИПНИКА члени гуртка — Любов ВАНАТ, Софія СЕМЕНЧУК, Мар’яна ШВЕЦЬ, Лілія ЯСТРЕМСЬКА — представили напрацювання щодо використання інформаційних та ігрових технологій у навчанні біології. Було обговорено питання участі у конференціях, публікаційної активності та популяризації результатів наукових досліджень.
Системна організація діяльності гуртка сприяє формуванню професійних, наукових і комунікативних компетентностей майбутніх учителів.

Донорство як складова соціально орієнтованої освіти
Протокол №6
24.12.2025. Важливим напрямом діяльності гуртка «Сучасні технології навчання біології» є формування соціальної відповідальності та громадянської свідомості студентської молоді.
Запрошена гостя — Людмила ЩЕРБАТЮК, директор Хмельницької філії ТОВ «Центр служби крові “Біофарма Плазма”», ознайомила учасників із біологічними, медичними та соціальними аспектами донорства. Було підкреслено значення донорської діяльності для збереження життя та здоров’я населення.
Поєднання біологічних знань із соціально значущими темами сприяє вихованню гуманістичних цінностей та професійної відповідальності майбутніх педагогів.

Наукові досягнення учасників гуртка: перемога у всеукраїнському конкурсі
29.12.2025
Підсумкове засідання гуртка «Сучасні технології навчання біології» було присвячене аналізу результатів наукової діяльності та участі студентів у всеукраїнських конкурсах наукових робіт.
Здобувачка освіти Яна НІКІТЮК виборола ІІ місце у Другому Всеукраїнському відкритому конкурсі наукових робіт імені Тимофія Дерев’янкіна з дослідженням, присвяченим упровадженню інтерактивної технології «Світове кафе» на уроках біології у 8 класі.
Науковий керівник Сергій СКРИПНИК зазначив, що участь у конкурсах сприяє формуванню наукової культури, дослідницьких умінь та професійної готовності майбутніх учителів біології та основ здоров’я.

